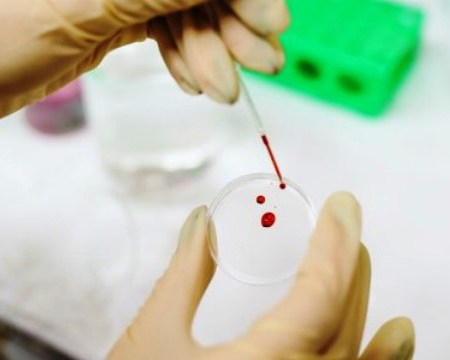

Autor: clipurbanodenoticias


Taller de Actuación Profesional: «El Rol del/a Abogado/a en la Audiencia de Mediación Previa Obligatoria»
FABA Informa: estudios presentados en el ESMO auguran un prometedor futuro en el ámbito del diagnóstico de tumores

Está disponible el Boletín semanal de noticias del Colegio de Farmacéuticos de la Provincia de Buenos Aires

FEPUBA llevará adelante el conversatorio «La salud mental en la pospandemia»

El Colegio de Profesionales de la Higiene y Seguridad firmó un convenio con el Instituto Superior de Formación Técnica en Imágenes Médicas de Pilar

El Colegio de Veterinarios Distrito 4 realizó un reconocimiento a colegas que cumplieron 25 años de matriculación

La FePRA invita al curso de extensión «El abordaje de las prácticas de encierro manicomial y los estudios de género»

Se dio a conocer el nuevo índice de la construcción
